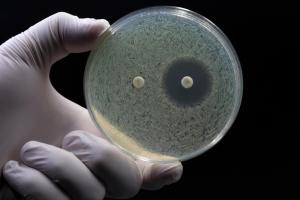
Antibiotic Resistance: The Impact of OTC Availability

Educating the public about the dangers of self-medication and the importance of finishing prescribed antibiotic courses plays a crucial role

Educating the public about the dangers of self-medication and the importance of finishing prescribed antibiotic courses plays a crucial role

Treatment often involves a complex daily routine of reconstitution and subcutaneous injection, along with strict storage requirements.

Although the CDC continues to emphasize that risk to humans is currently low, patients will have questions.
Published: November 6th 2024 | Updated: